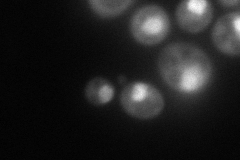
YER021W
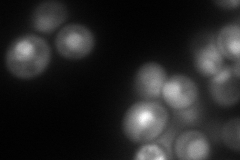
YER021W
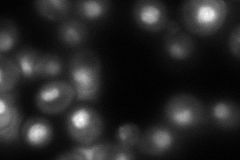
YER021W

View description
Essential, non-ATPase regulatory subunit of the 26S proteasome lid, similar to the p58 subunit of the human 26S proteasome; temperature-sensitive alleles cause metaphase arrest, suggesting a role for the proteasome in cell cycle control
Localization:
Intensity:
Fold change:
Significance:
-
C’ GFP library in SD

below threshold16.7 -
N' NOP1pr-GFP in SD
nucleus103.324 -
N' TEF2pr-mCherry in SD
nucleus142.968 -
N' NATIVEpr-GFP in SD
nucleus143.954 -
N' TEF2pr-VC and Cyto-VN in SD

#N/A0 -
C’ GFP library in SD+DTT

cytosol19.21.14No -
C’ GFP library in SD+H2O2

cytosol16.570.99No -
C’ GFP library in Starvation Media

cytosol15.650.93No -
C’ GFP library on the background of Pup2-DaMP

below threshold -
C’ GFP library on the background of CCT mutant

below threshold19.54551.16982No
